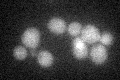
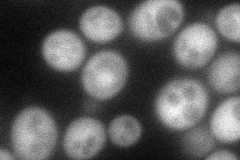
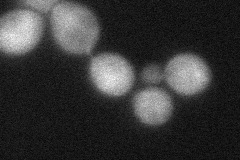

View description
Guanine nucleotide dissociation stimulator for Sec4p, functions in the post-Golgi secretory pathway; binds zinc, found both on membranes and in the cytosol
Localization:
Intensity:
Fold change:
Significance:
-
C’ GFP library in SD
cytosol26.15 -
N' NOP1pr-GFP in SD
cytosol80.8704 -
N' TEF2pr-mCherry in SD

missing0 -
N' NATIVEpr-GFP in SD

cytosol29.6512 -
N' TEF2pr-VC and Cyto-VN in SD
cytosol44.6613 -
C’ GFP library in SD+DTT

cytosol26.451.01No -
C’ GFP library in SD+H2O2

cytosol21.880.83No -
C’ GFP library in Starvation Media

cytosol29.31.12No -
C’ GFP library on the background of Pup2-DaMP

cytosol -
C’ GFP library on the background of CCT mutant

cytosol21.54160.82346No
